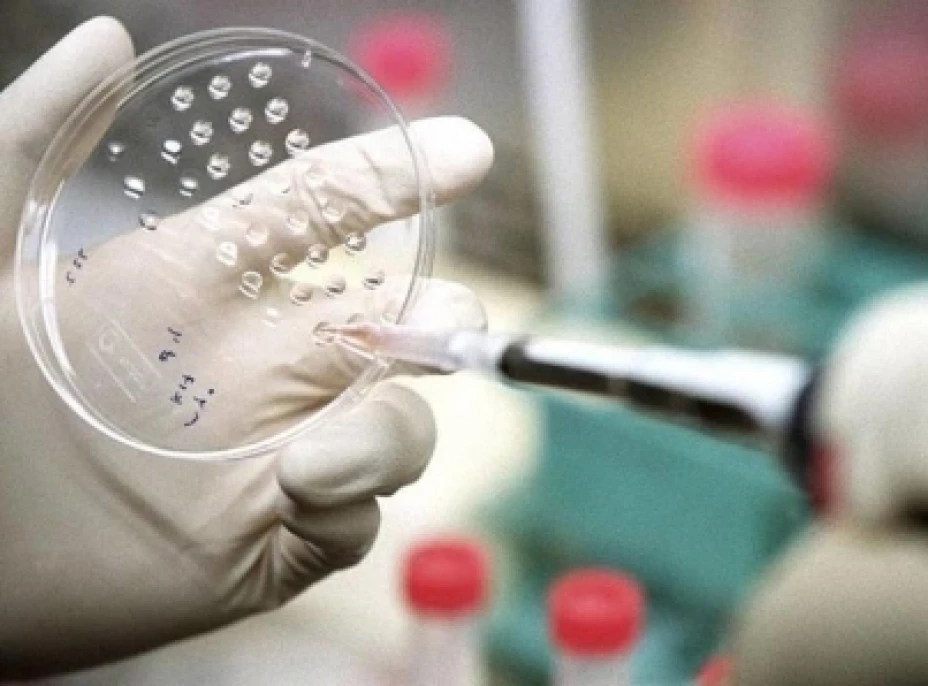
Inhibidor de cáncer

México, 7 Mayo.- La molécula llamada resveratrol, que se encuentra en uvas rojas, moras y cacahuates, es un antioxidante con beneficios cardiovasculares y antienvejecimiento, que puede ser clave para combatir la resistencia a la quimioterapia, principal causa del fracaso en el tratamiento de cáncer.
El análisis de los especialistas del Departamento de Genética y Biología Molecular del Centro de Investigación y de Estudios Avanzados (Cinvestav), encabezado por Patricio Gariglio Vidal y Jaime García Mena, identificaron los medios por los que este compuesto natural inhibe la propagación de las células cancerosas y elimina la resistencia que generan medicamentos como el cisplatino, usado en el tratamiento de diversos tipos de cáncer.
Sin embargo, este fármaco provoca varios efectos secundarios como trastornos de la percepción y la audición, además genera resistencia.
Destacaron que al combinarse el resveratrol con el cisplatino, se eliminan las resistencias que las células podrían haber generado en un tratamiento de quimioterapia, también disminuye la cantidad de cisplatino suministrado, lo que reduce las secuelas secundarias.
En un comunicado del centro de investigación, Jorge Arturo Hernández, egresado del doctorado de ese Departamento, señaló que la investigación fue desarrollada en una línea celular de cáncer de mama resistente a cisplatino.
“Al observar que esta combinación inhibía la proliferación celular y eliminaba la resistencia de las células, nos dedicamos a descifrar el mecanismo molecular por el cual el resveratrol quita los obstáculos para activar mecanismos de apoptosis (muerte celular programada)”, indicó.
Este estudio publicado en la revista científica “Nutrients”, señaló que el resveratrol es un compuesto natural al que se le han atribuido diversas propiedades; una de las que más ha llamado la atención es para apoyar a combatir el cáncer, ya que se ha visto que protege las células sanas que están a la periferia de los tumores y no genera toxicidad en los seres humanos.